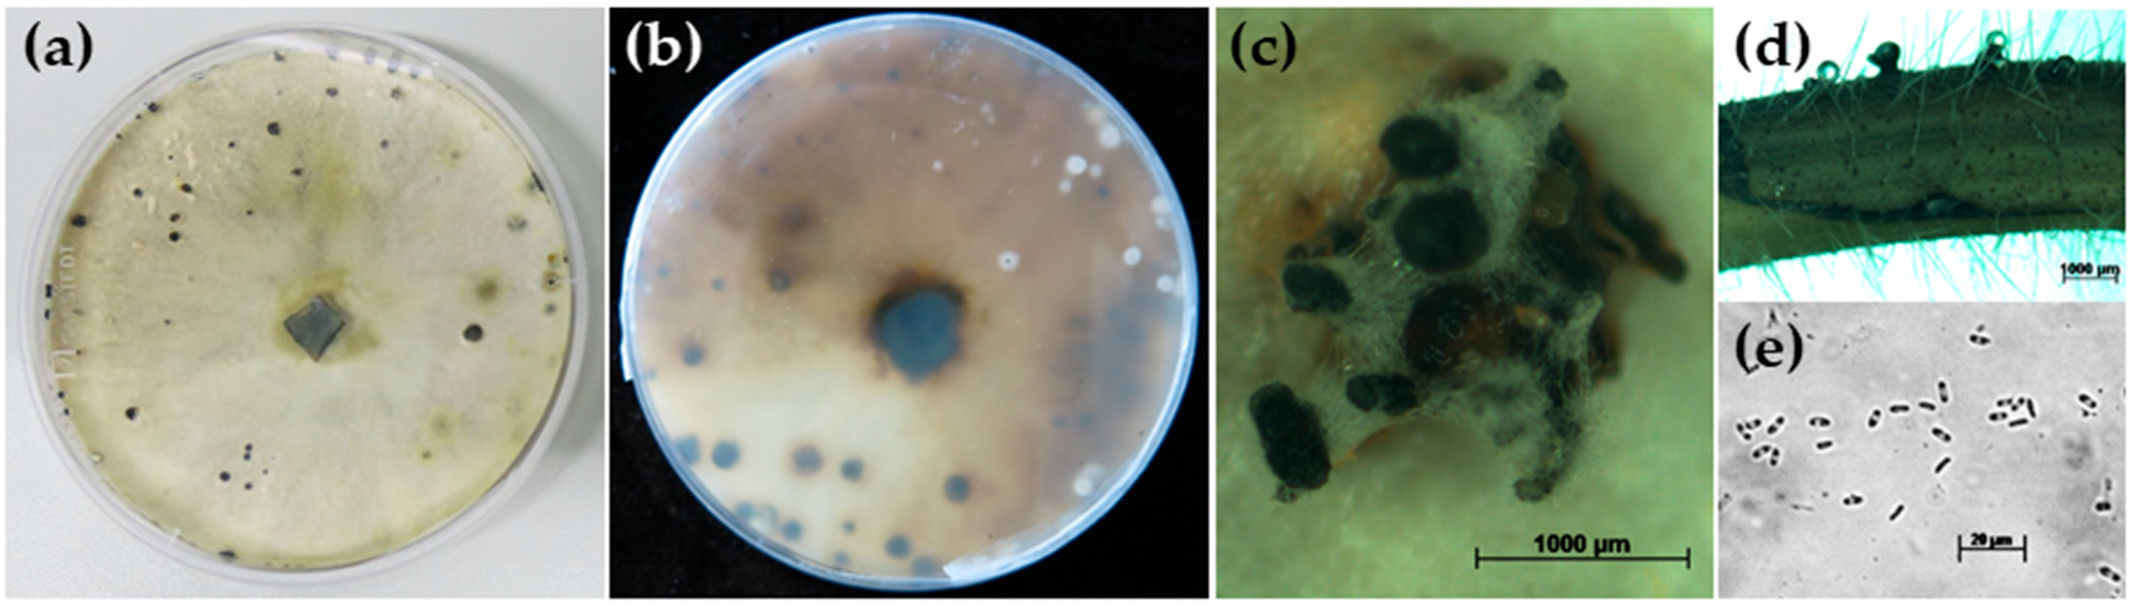
Jof 10 00803 g002

First Report of Diaporthe goulteri on Soybean in Germany
Abstract
1. Introduction
2. Materials and Methods
2.1. Sampling and Isolation
2.2. Species Identification
2.2.1. Species Identification from Pure Cultures Using Culture Morphology and Microscopy as Well as Sequencing and Phylogenetic Analysis
2.2.2. Direct Species Identification from Infected Plant Parts Using qPCR
2.3. Testing for Pathogenicity on Soybean
3. Results
3.1. D. goulteri Found on a Soybean Plant Collected in a Field Close to Tübingen, Germany
3.2. Morphological Description of D. goulteri Isolate DPC_HOH36
3.3. D. goulteri Can Infect Soybean in the Laboratory Test
4. Discussion
Author Contributions
Funding
Institutional Review Board Statement
Informed Consent Statement
Data Availability Statement
Acknowledgments
Conflicts of Interest
References
- Pioli, R.N.; Morandi, E.N.; Bisaro, V. First report of Soybean Stem Canker caused by Diaporthe phaseolorum var. caulivora in Argentina. Plant Dis. 2001, 85, 95. [Google Scholar] [CrossRef] [PubMed]
- Costamilan, L.M.; Yorinori, J.T.; Almeida, A.M.; Seixas, C.D.S.; Binneck, E.; Araújo, M.R.; Carbonari, J.A. First report of Diaporthe phaseolorum var. caulivora infecting soybean plants in Brazil. Trop. Plant Pathol. 2008, 33, 381–385. [Google Scholar] [CrossRef]
- Santos, J.M.; Vrandečić, K.; Ćosić, J.; Duvnjak, T.; Phillips, A.J.L. Resolving the Diaporthe species occurring on soybean in Croatia. Persoonia 2011, 27, 9–19. [Google Scholar] [CrossRef] [PubMed]
- Zhao, X.; Li, K.; Zheng, S.; Yang, J.; Chen, C.; Zheng, X.; Wang, Y.; Ye, W. Diaporthe diversity and pathogenicity revealed from a broad survey of Soybean Stem Blight in China. Plant Dis. 2022, 106, 2892–2903. [Google Scholar] [CrossRef] [PubMed]
- Petrović, K.; Riccioni, L.; Vidić, M.; Đorđević, V.; Balešević-Tubić, S.; Đukić, V.; Miladinov, Z. First report of Diaporthe novem, D. foeniculina, and D. rudis associated with soybean seed decay in Serbia. Plant Dis. 2016, 100, 2324. [Google Scholar] [CrossRef]
- Petrović, K.; Skaltsas, D.; Castlebury, L.A.; Kontz, B.; Allen, T.W.; Chilvers, M.I.; Gregory, N.; Kelly, H.M.; Koehler, A.M.; Kleczewski, N.M.; et al. Diaporthe seed decay of soybean [Glycine max (L.) Merr.] is endemic in the United States, but new fungi are involved. Plant Dis. 2021, 105, 1621–1629. [Google Scholar] [CrossRef]
- Hosseini, B.; El-Hasan, A.; Link, T.; Voegele, R.T. Analysis of the species spectrum of the Diaporthe/Phomopsis complex in European soybean seeds. Mycol. Prog. 2020, 19, 455–469. [Google Scholar] [CrossRef]
- Hosseini, B.; Voegele, R.T.; Link, T.I. Diagnosis of soybean diseases caused by fungal and oomycete pathogens: Existing methods and new developments. J. Fungi 2023, 9, 587. [Google Scholar] [CrossRef]
- Gomes, R.R.; Glienke, C.; Videira, S.I.R.; Lombard, L.; Groenewald, J.Z.; Crous, P.W. Diaporthe: A genus of endophytic, saprobic and plant pathogenic fungi. Persoonia 2013, 31, 1–41. [Google Scholar] [CrossRef]
- Udayanga, D.; Castlebury, L.A.; Rossman, A.Y.; Hyde, K.D. Species limits in Diaporthe: Molecular re-assessment of D. citri, D. cytosporella, D. foeniculina and D. rudis. Persoonia 2014, 32, 83–101. [Google Scholar] [CrossRef]
- Santos, L.; Alves, A.; Alves, R. Evaluating multi-locus phylogenies for species boundaries determination in the genus Diaporthe. PeerJ 2017, 5, e3120. [Google Scholar] [CrossRef] [PubMed]
- Thompson, S.; Tan, Y.P.; Shivas, R.G.; Neate, S.; Morin, L.; Bissett, A.; Aitken, E. Green and brown bridges between weeds and crops reveal novel Diaporthe species in Australia. Persoonia 2015, 35, 39–49. [Google Scholar] [CrossRef] [PubMed]
- Bundhun, D.; Senanayake, I.; Jayawardena, R.S.; Camporesi, E.; Huang, Y.; Dong, Z.; Hyde, K.D.; To-Anun, C.; Cheewangkoon, R. First reports of the sexual morphs of Diaporthe forlicesenica nom. nov. and Diaporthe goulteri (Diaporthaceae, Diaporthales) revealed by molecular phylogenetics. Phytotaxa 2021, 516, 1–27. [Google Scholar] [CrossRef]
- Liu, D.; Coloe, S.; Baird, R.; Pedersen, J. Rapid mini-preparation of fungal DNA for PCR. J. Clin. Microbiol. 2000, 38, 471. [Google Scholar] [CrossRef]
- White, T.J.; Bruns, T.; Lee, S.; Taylor, J. Amplification and direct sequencing of fungal ribosomal RNA genes for phylogenetics. In PCR Protocols: A Guide to Methods and Applications; Innis, N., Gelfand, D., Sninsky, J., White, T., Eds.; Academic Press Inc.: New York, NY, USA, 1990; pp. 315–322. [Google Scholar]
- Carbone, I.; Kohn, L.M. A method for designing primer sets for speciation studies in filamentous ascomycetes. Mycologia 1999, 91, 553–556. [Google Scholar] [CrossRef]
- Glass, N.L.; Donaldson, G.C. Development of primer sets designed for use with the PCR to amplify conserved genes from filamentous ascomycetes. Appl. Environ. Microbiol. 1995, 61, 1323–1330. [Google Scholar] [CrossRef]
- Thompson, J.D.; Higgins, D.G.; Gibson, T.J. CLUSTAL W: Improving the sensitivity of progressive multiple sequence alignment through sequence weighting, position-specific gap penalties and weight matrix choice. Nucleic Acids Res. 1994, 22, 4673–4680. [Google Scholar] [CrossRef]
- Hall, T.A. BioEdit: A user-friendly biological sequence alignment editor and analysis program for Windows 95/98/NT. Nucleic Acids Symp. Ser. 1999, 41, 95–98. [Google Scholar]
- Tamura, K.; Nei, M. Estimation of the number of nucleotide substitutions in the control region of mitochondrial DNA in humans and chimpanzees. Mol. Biol. Evol. 1993, 10, 512–526. [Google Scholar] [CrossRef]
- Kumar, S.; Stecher, G.; Li, M.; Knyaz, C.; Tamura, K. MEGA X: Molecular Evolutionary Genetic Analysis across computing platforms. Mol. Biol. Evol. 2018, 35, 1547–1549. [Google Scholar] [CrossRef]
- Hosseini, B.; Voegele, R.T.; Link, T.I. Establishment of a quadruplex real-time PCR assay to distinguish the fungal pathogens Diaporthe longicolla, D. caulivora, D. eres, and D. novem on soybean. PLoS ONE 2021, 16, e0257225. [Google Scholar] [CrossRef] [PubMed]
- Ghimire, K.; Petrović, K.; Kontz, B.J.; Bradley, C.A.; Chilvers, M.I.; Mueller, D.S.; Smith, D.L.; Wise, K.A.; Mathew, F.M. Inoculation method impacts symptom development associated with Diaporthe aspalathi, D. caulivora, and D. longicolla on soybean (Glycine max). Plant Dis. 2019, 103, 677–684. [Google Scholar] [CrossRef] [PubMed]
- Campbell, M.A.; Li, Z.; Buck, J.W. Development of southern stem canker disease on soybean seedlings in the greenhouse using a modified toothpick inoculation assay. Crop Protect. 2017, 100, 57–64. [Google Scholar] [CrossRef]

| Species | Designation * | Accession Numbers | ||
|---|---|---|---|---|
| ITS | TUB | TEF | ||
| D. ambigua | CBS 114015 | MH862953 | KC343978 | GQ250299 |
| Isolate DAB-1 | MK463859 | MK463861 | ||
| D. caulivora | DPC_HOH2 | MK024677 | MK161476 | MK099094 |
| CBS 127268 | HM347712 | KC344013 | HM347691 | |
| D. eres | DPC_HOH3 | MK024678 | MK161477 | MK099095 |
| DPC_HOH10 | MK024685 | MK161484 | MK099102 | |
| CPC 30111 | MG281083 | MG281256 | MG281604 | |
| D. goulteri | DPC_HOH36 | PQ008930 | PQ014385 | PQ014381 |
| Strain BRIP 55657a | KJ197290 | KJ197270 | KJ197252 | |
| Isolate MFLUCC 21-0012 | MW677456 | MW680162 | MW680164 | |
| Strain AIL-R-03 | ON221693 | |||
| Strain GLY8 | MF356582 | |||
| Isolate NTOU 4494 | MZ422958 | |||
| D. longicolla | DPC_HOH1 | MK024676 | MK161475 | MK099093 |
| Strain SSLP-1 | HQ333510 | |||
| CBS 127267 | HM347700 | HM347685 | ||
| D. novem | DPC_HOH8 | MK024683 | MK161482 | MK099100 |
| DPC_HOH15 | MK024690 | MK161489 | MK099107 | |
| CBS 127271 | HM347710 | KC344125 | HM347695 | |
Disclaimer/Publisher’s Note: The statements, opinions and data contained in all publications are solely those of the individual author(s) and contributor(s) and not of MDPI and/or the editor(s). MDPI and/or the editor(s) disclaim responsibility for any injury to people or property resulting from any ideas, methods, instructions or products referred to in the content. |
© 2024 by the authors. Licensee MDPI, Basel, Switzerland. This article is an open access article distributed under the terms and conditions of the Creative Commons Attribution (CC BY) license (https://creativecommons.org/licenses/by/4.0/).
Share and Cite
Hosseini, B.; Gröbner, M.G.; Link, T.I. First Report of Diaporthe goulteri on Soybean in Germany. J. Fungi 2024, 10, 803. https://doi.org/10.3390/jof10110803
Hosseini B, Gröbner MG, Link TI. First Report of Diaporthe goulteri on Soybean in Germany. Journal of Fungi. 2024; 10(11):803. https://doi.org/10.3390/jof10110803
Chicago/Turabian StyleHosseini, Behnoush, Maximilian Gerhard Gröbner, and Tobias Immanuel Link. 2024. "First Report of Diaporthe goulteri on Soybean in Germany" Journal of Fungi 10, no. 11: 803. https://doi.org/10.3390/jof10110803
APA StyleHosseini, B., Gröbner, M. G., & Link, T. I. (2024). First Report of Diaporthe goulteri on Soybean in Germany. Journal of Fungi, 10(11), 803. https://doi.org/10.3390/jof10110803

